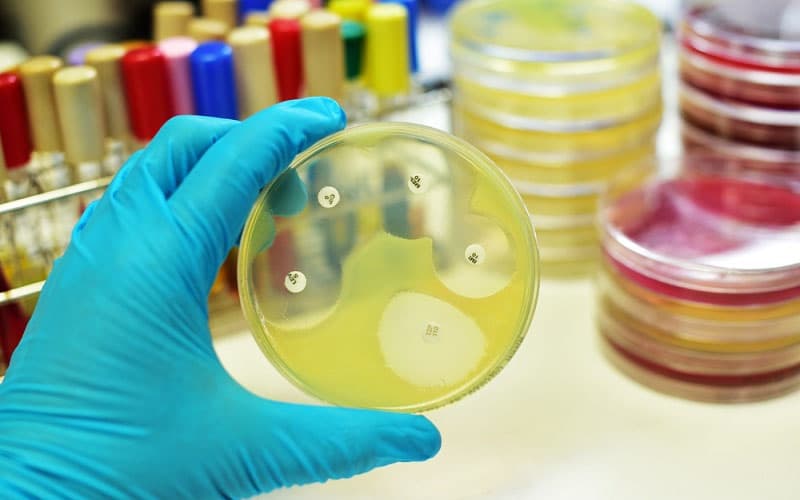
phổ kháng khuẩn của kháng sinh

Phổ kháng khuẩn của kháng sinh là gì?
Trong điều trị các bệnh nhiễm khuẩn, việc lựa chọn đúng loại kháng sinh là yếu tố quyết định thành công. Để làm được điều này, các bác sĩ cần dựa trên một khái niệm quan trọng: “phổ kháng khuẩn của kháng sinh”. Vậy cụ thể “phổ kháng khuẩn là gì”? Hiểu một cách đơn giản, đây là phạm vi tác dụng của một loại kháng sinh, cho biết nó có khả năng tiêu diệt hoặc kìm hãm những nhóm vi khuẩn nào.
1. Phổ kháng khuẩn của kháng sinh là gì?
Trong y học hiện đại, việc sử dụng kháng sinh hiệu quả là chìa khóa để kiểm soát các bệnh truyền nhiễm. Tuy nhiên, không phải loại kháng sinh nào cũng tiêu diệt được mọi loại vi khuẩn. Sự khác biệt này nằm ở “phổ kháng khuẩn”. Hiểu rõ phổ kháng khuẩn của kháng sinh là nền tảng cốt lõi để các bác sĩ đưa ra phác đồ điều trị chính xác, hạn chế tình trạng kháng thuốc đang báo động trên toàn cầu.
Về mặt thuật ngữ chuyên môn, phổ kháng khuẩn của kháng sinh đề cập đến phạm vi các loại vi sinh vật (vi khuẩn) mà một loại thuốc kháng sinh cụ thể có khả năng ức chế sự phát triển hoặc tiêu diệt hoàn toàn. Nói cách khác, đây là “danh sách mục tiêu” mà kháng sinh có thể nhắm trúng.
Khái niệm này giúp phân biệt khả năng hoạt động của thuốc. Có những thuốc chỉ đánh vào một nhóm nhỏ vi khuẩn (phổ hẹp), trong khi số khác lại tấn công diện rộng (phổ rộng). Phổ hoạt động của thuốc kháng khuẩn liên quan đến sự đa dạng của các vi khuẩn mục tiêu. Một chất kháng khuẩn phổ hẹp chỉ nhắm vào các tập hợp con cụ thể của mầm bệnh vi khuẩn. Ví dụ: một số thuốc phổ hẹp chỉ nhắm vào vi khuẩn Gram dương, trong khi những thuốc khác chỉ nhắm vào vi khuẩn Gram âm.

2. Các yếu tố ảnh hưởng đến phổ kháng khuẩn của kháng sinh
Phổ kháng khuẩn của kháng sinh không phải là một đặc tính bất biến. Nó có thể thay đổi theo thời gian và không gian do sự tiến hóa của vi khuẩn. Thực tế lâm sàng cho thấy phổ kháng khuẩn kháng sinh chịu ảnh hưởng bởi nhiều yếu tố:
- Cơ chế tác động của thuốc: Kháng sinh tấn công vào vách tế bào (như Beta-lactam) sẽ có phổ khác với kháng sinh ức chế tổng hợp protein (như Macrolid). Cấu trúc của vi khuẩn (Gram âm có lớp màng ngoài dày khó thâm nhập) quyết định liệu thuốc có thể tấn công hay không.
- Đề kháng tự nhiên: Một số vi khuẩn sinh ra đã có khả năng chống lại một số nhóm thuốc nhất định (ví dụ: Mycoplasma không có vách tế bào nên kháng hoàn toàn với các thuốc ức chế tổng hợp vách).
- Đề kháng thu nhận: Đây là yếu tố quan trọng nhất làm thu hẹp phổ kháng khuẩn. Vi khuẩn đột biến gen hoặc nhận gen kháng thuốc từ vi khuẩn khác, khiến một loại kháng sinh trước đây hiệu quả này trở nên vô tác dụng.
3. Phân loại phổ kháng khuẩn theo nhóm vi khuẩn
Để dễ dàng lựa chọn thuốc, các nhà dược lý học thường phân loại dựa trên độ rộng của phổ:
- Kháng sinh phổ hẹp: Chỉ tác dụng lên một nhóm vi khuẩn đặc hiệu (ví dụ: chỉ Gram dương hoặc chỉ Gram âm). Ưu điểm của nhóm này là ít gây rối loạn hệ vi sinh vật thường trú của cơ thể (microbiome).
- Kháng sinh phổ rộng: Tác dụng lên nhiều nhóm vi khuẩn, bao gồm cả Gram dương và Gram âm, đôi khi cả vi khuẩn kỵ khí. Nhóm này thường được dùng khi chưa xác định rõ nguyên nhân gây bệnh, nhưng nhược điểm là dễ gây loạn khuẩn đường ruột và gia tăng tỷ lệ kháng thuốc.

4. Phổ kháng khuẩn của các nhóm kháng sinh thường gặp
Phổ kháng khuẩn của các nhóm kháng sinh quyết định trực tiếp đến việc kê đơn. Mỗi nhóm thuốc có thế mạnh riêng trên từng loại vi khuẩn: Gram dương (G+), Gram âm (G-), Kỵ khí hay Vi khuẩn nội bào/không điển hình.
Dưới đây là bảng tổng hợp chi tiết phổ kháng khuẩn của các nhóm kháng sinh chính:
| Nhóm Kháng Sinh | Đại diện thường gặp | Gram Dương (G+) | Gram Âm (G-) | Vi khuẩn Kỵ khí | Vi khuẩn Nội bào / Không điển hình |
|---|---|---|---|---|---|
| Penicillins tự nhiên | Penicillin G, V | Rất mạnh (Liên cầu, Phế cầu) | Yếu / Hầu như không | Một số chủng | Không |
| Penicillins phổ rộng | Amoxicillin, Ampicillin | Tốt | Tốt hơn Penicillin G (E.coli, H.influenzae) | Kém | Không |
| Cephalosporins thế hệ 1 | Cephalexin, Cefazolin | Rất mạnh (Tụ cầu, Liên cầu) | Yếu (Một số trược khuẩn đường ruột) | Kém | Không |
| Cephalosporins thế hệ 3 | Ceftriaxone, Cefotaxime, Ceftazidime | Khá (Kém hơn thế hệ 1 trên Tụ cầu) | Rất mạnh (Bao gồm cả trực khuẩn mủ xanh – với Ceftazidime) | Kém | Không |
| Carbapenems | Imipenem, Meropenem | Rất mạnh | Rất mạnh (Đa kháng) | Rất mạnh | Không |
| Aminoglycosides | Gentamicin, Amikacin | Tốt (thường phối hợp với Beta-lactam để hiệp đồng) | Rất mạnh (Trực khuẩn G- hiếu khí) | Không tác dụng | Một số (như Mycobacteria) |
| Macrolides | Erythromycin, Azithromycin, Clarithromycin | Tốt | Yếu (trừ một số chủng hô hấp) | Kém | Rất mạnh (Mycoplasma, Chlamydia, Legionella) |
| Fluoroquinolones | Ciprofloxacin, Levofloxacin | Tốt (Levofloxacin mạnh trên phế cầu) | Rất mạnh (Trực khuẩn mủ xanh, đường ruột) | Kém (trừ Moxifloxacin) | Mạnh |
| Tetracyclines | Doxycycline, Tetracycline | Tốt | Tốt | Một số chủng | Rất mạnh (Rickettsia, Chlamydia) |
| Nitroimidazoles | Metronidazole | Không | Không | Rất mạnh (Đặc hiệu cho kỵ khí) | Một số đơn bào (Amip) |
5. Ứng dụng phổ kháng khuẩn trong lựa chọn kháng sinh
Sau khi đã hiểu phổ kháng khuẩn của kháng sinh là gì, việc áp dụng vào thực tế lâm sàng cần tuân theo hai chiến lược chính:
5.1. Điều trị theo kinh nghiệm
Khi bệnh nhân nhập viện với tình trạng nhiễm trùng cấp tính (ví dụ: viêm phổi, sốc nhiễm khuẩn), bác sĩ không thể chờ đợi kết quả nuôi cấy vi khuẩn (thường mất 2-3 ngày). Lúc này, bác sĩ sẽ dựa vào dịch tễ học và vị trí nhiễm trùng để dự đoán vi khuẩn gây bệnh.
- Họ sẽ chọn loại thuốc có phổ kháng khuẩn của kháng sinh bao phủ được các tác nhân nghi ngờ nhất.
- Ví dụ: Viêm phổi cộng đồng thường do Phế cầu (G+) hoặc vi khuẩn không điển hình, nên thường chọn Beta-lactam phối hợp Macrolid hoặc dùng Quinolone hô hấp.
5.2. Điều trị đích và xuống thang điều trị
Khi đã có kết quả kháng sinh đồ (biết chính xác tên vi khuẩn và độ nhạy cảm), bác sĩ cần đánh giá lại:
- Nếu đang dùng kháng sinh phổ rộng, cần chuyển sang kháng sinh phổ hẹp hơn nhưng đặc hiệu với vi khuẩn đó.
- Chiến lược này gọi là “xuống thang”, giúp giảm thiểu tác dụng phụ, tiết kiệm chi phí và bảo tồn phổ kháng khuẩn của các thuốc mạnh cho những trường hợp nguy kịch sau này.
Lưu ý rằng phổ kháng khuẩn kháng sinh trên in vitro (trong phòng thí nghiệm) có thể khác biệt đôi chút so với in vivo (trong cơ thể người) do khả năng hấp thu và phân bố thuốc tại mô.

6. Cách sử dụng kháng sinh dựa trên phổ kháng khuẩn an toàn
Để đảm bảo an toàn cho bệnh nhân và cộng đồng, việc sử dụng thuốc dựa trên phổ kháng khuẩn cần tuân thủ các nguyên tắc:
- Đúng thuốc – Đúng bệnh: Không dùng kháng sinh (thuốc diệt vi khuẩn) cho các bệnh do virus (cúm, cảm lạnh). Phổ kháng khuẩn của kháng sinh hoàn toàn không bao gồm virus.
- Ưu tiên phổ hẹp: Luôn ưu tiên kháng sinh phổ hẹp nếu đã xác định được vi khuẩn. Việc lạm dụng phổ kháng khuẩn của các nhóm kháng sinh phổ rộng (như Carbapenem hay Cephalosporin thế hệ cao) cho các nhiễm trùng thông thường sẽ thúc đẩy vi khuẩn đa kháng thuốc phát triển.
- Đủ liều và đủ thời gian: Phổ tác dụng chỉ đạt được khi nồng độ thuốc tại ổ nhiễm khuẩn đạt mức ức chế tối thiểu. Dùng thiếu liều sẽ không tiêu diệt hết vi khuẩn nằm trong vùng phổ nhạy cảm, tạo điều kiện cho các chủng đề kháng sống sót.
- Cập nhật kiến thức: Vì phổ kháng khuẩn thay đổi theo tình hình kháng thuốc tại địa phương, các bác sĩ cần liên tục cập nhật dữ liệu vi sinh tại bệnh viện mình công tác.
Tóm lại, phổ kháng khuẩn của kháng sinh giúp bác sĩ lựa chọn được loại thuốc phù hợp nhất với chủng vi khuẩn gây bệnh, tránh tình trạng kê đơn quá rộng hoặc không đúng mục tiêu. Từ đó, không chỉ nâng cao hiệu quả điều trị cho bệnh nhân mà còn góp phần quan trọng vào cuộc chiến chống lại tình trạng kháng thuốc đang ngày càng gia tăng.